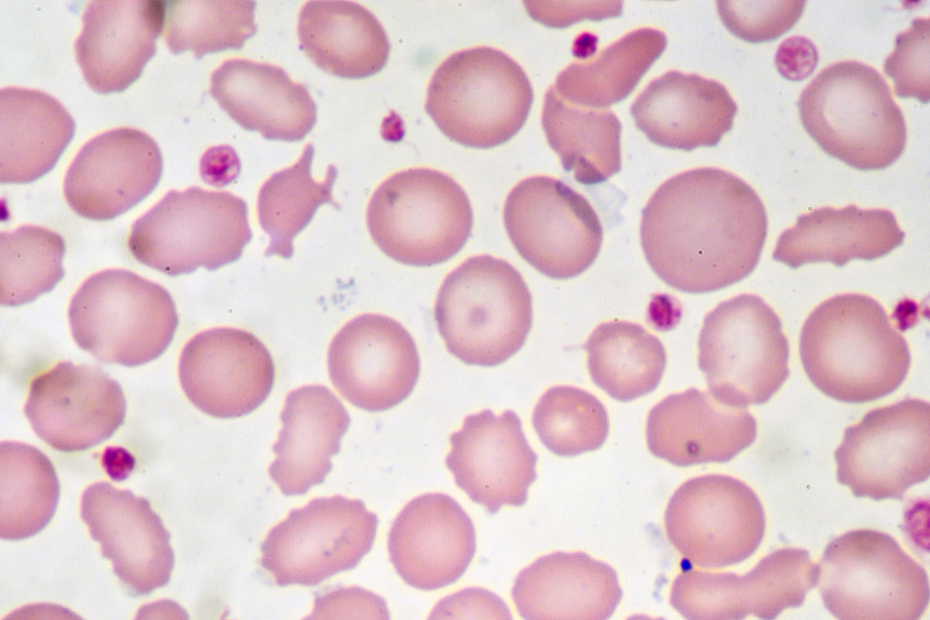
Vitamina B12 e anemia: hemácias observadas em lâmina de sangue

Vitamina B12 e anemia: qual a relação e quando investigar
Vitamina B12 e anemia estão diretamente relacionadas, especialmente em casos de cansaço persistente, palidez, fraqueza… Continue a ler »Vitamina B12 e anemia: qual a relação e quando investigar